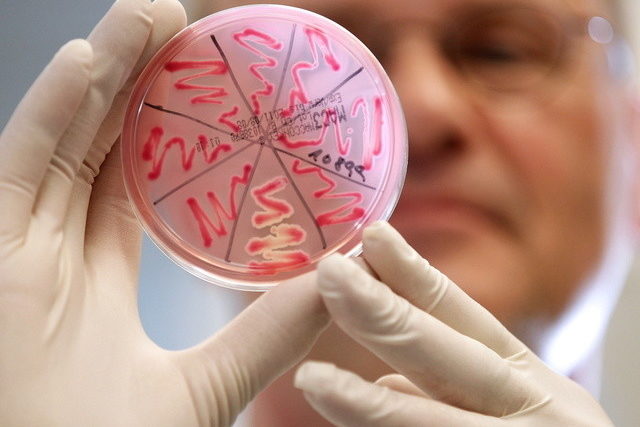

Der Grossteil der im Frühling 2011 in Deutschland am Darmerreger EHEC erkrankten Menschen ist wieder völlig gesund. Nur wenige der nach neuesten Erkenntnissen 4800 Betroffenen sind noch in Behandlung.
Dies sagte Joachim Röther, Vize-Vorsitzender der Deutschen Schlaganfallgesellschaft (DSG), in Berlin bei einer Tagung von Neurologen. Allerdings habe ein niedriger Prozentsatz der rund 850 Menschen, die nach EHEC an dem aggressiveren HUS erkrankten, bleibende neurologische Schäden davongetragen.
Sie litten etwa an Bewegungs- oder Sprachstörungen. HUS, das hämolytisch-urämische Syndrom, ist der schwere Krankheitsverlauf von EHEC und verursacht Nierenschäden. 53 EHEC-Erkrankte, darunter 35 HUS-Patienten starben in Deutschland.